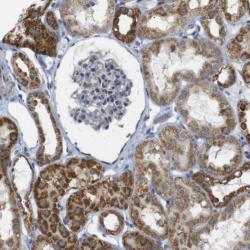

Antibody data
- Antibody Data
- Antigen structure
- References [5]
- Comments [0]
- Validations
- Western blot [1]
- Immunohistochemistry [1]
Submit
Validation data
Reference
Comment
Report error
- Product number
- sc-11412 - Provider product page

- Provider
- Santa Cruz Biotechnology
- Proper citation
- Santa Cruz Biotechnology Cat#sc-11412, RRID:AB_2155949
- Product name
- Anti-NR3C2
- Antibody type
- Polyclonal
- Antigen
- Recombinant full-length protein
- Reactivity
- Human
- Host
- Rabbit
Submitted references Prenatal synthetic glucocorticoid exposure alters hypothalamic-pituitary-adrenal regulation and pregnancy outcomes in mature female guinea pigs.
Aldosterone activates endothelial exocytosis.
Hepatocyte nuclear factor-1alpha regulates glucocorticoid receptor expression to control postnatal body growth.
Molecular regulation of the hypothalamic-pituitary-adrenal axis in adult male guinea pigs after prenatal stress at different stages of gestation.
Effects of repeated prenatal glucocorticoid exposure on long-term potentiation in the juvenile guinea-pig hippocampus.
Dunn E, Kapoor A, Leen J, Matthews SG
The Journal of physiology 2010 Mar 1;588(Pt 5):887-99
The Journal of physiology 2010 Mar 1;588(Pt 5):887-99
Aldosterone activates endothelial exocytosis.
Jeong Y, Chaupin DF, Matsushita K, Yamakuchi M, Cameron SJ, Morrell CN, Lowenstein CJ
Proceedings of the National Academy of Sciences of the United States of America 2009 Mar 10;106(10):3782-7
Proceedings of the National Academy of Sciences of the United States of America 2009 Mar 10;106(10):3782-7
Hepatocyte nuclear factor-1alpha regulates glucocorticoid receptor expression to control postnatal body growth.
Lin WY, Hu YJ, Lee YH
American journal of physiology. Gastrointestinal and liver physiology 2008 Sep;295(3):G542-51
American journal of physiology. Gastrointestinal and liver physiology 2008 Sep;295(3):G542-51
Molecular regulation of the hypothalamic-pituitary-adrenal axis in adult male guinea pigs after prenatal stress at different stages of gestation.
Kapoor A, Leen J, Matthews SG
The Journal of physiology 2008 Sep 1;586(17):4317-26
The Journal of physiology 2008 Sep 1;586(17):4317-26
Effects of repeated prenatal glucocorticoid exposure on long-term potentiation in the juvenile guinea-pig hippocampus.
Setiawan E, Jackson MF, MacDonald JF, Matthews SG
The Journal of physiology 2007 Jun 15;581(Pt 3):1033-42
The Journal of physiology 2007 Jun 15;581(Pt 3):1033-42
No comments: Submit comment
Supportive validation
- Submitted by
- per
- Main image

- Experimental details
- Western blot analysis of antibody specificity using a routine panel composed of IgG/HSA-depleted human plasma and protein lysates from selected human tissues and cell lines.
- Validation comment
- Band of predicted size in kDa (+/-20%) with additional bands present.
- Primary Ab dilution
- 1:500
- Secondary Ab dilution
- 1:3000
- Lane 1
- Marker [kDa]: 213, 118, 83, 50, 33, 26, 18
- Lane 2
- RT-4
- Lane 3
- U-251MG sp
- Lane 4
- Human Plasma
- Lane 5
- Liver
- Lane 6
- Tonsil
- Theoretical target weight
- [kDa] 108
Supportive validation
- Submitted by
- per
- Main image
- Experimental details
- Immunohistochemical staining of human kidney shows distinct granular cytoplasmic positivity in cells in tubules.
- Validation comment
- Staining pattern consistent with experimental and/or bioinformatic data.